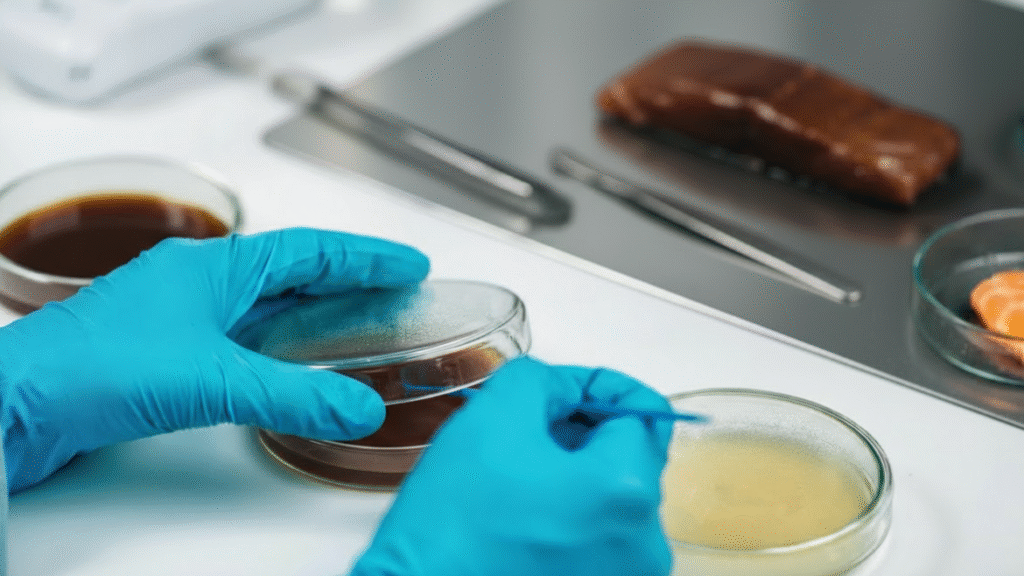

About Foodtest
A culture of health, built on science and trust.
built on science and trust.
Foodtest combines convenient at-home sample collection with laboratory-grade analysis and nutrition follow-up to deliver results you can rely on. Based in India, our mission is to make accurate food intolerance and allergy testing simple, accessible, and empowering for everyone.
What Is Food Intolerance?
Food intolerance means your body struggles with digestion or irritates your digestive system. It occurs when the body lacks the enzymes necessary for digestion.
If you frequently suffer from health issues like

Bloating

Fatigue
Weight Issues

Constipation

Headache

Skin Problems
Well it could be due to eating the wrong food that your body has difficulty in digesting.
What Is Food Allergy?
An allergy is the reaction of the body’s immune system to normally harmless substances such as pollen, various foods, house dust mites, etc. The immune system can overreact by producing antibodies that attack the allergen.
If you frequently suffer from health issues like

Itching

Trouble Breathing

Hives or Rash

Headache

Sneezing

Runny Nose
Well it could be due to some allergy that your body has from allergens like food, dust, pollen, pet hair, etc.
How It Works
Simple 4-Step Process

Choose your test
Choose the most appropriate food allergy test for you. Have a blood sample taken in a laboratory or at home.

Receive Your Results
A digital copy of your food allergy test results will be sent to you by secure email.

Meet With A Dietician
Your nutritionist will offer you personalized nutritional advice based on your test results and needs.

Become a Healthier You!
You are unique. Thank you to the food allergy testing options and nutritional advice, you can now also nourish your body uniquely.
Intolerance Test vs Allergy Test
Intolerance Test
vs Allergy Test
Understanding the difference is crucial for your health. Both tests help identify problematic foods, but they work differently.


Food Intolerance Test
IgG Antibody Testing
Starts @₹7,000/-
Detect Delayed Food Sensitivities

2 Panels available
58+ foods (standard) up to 200+ expanded options

Common Symptoms
Bloating, fatigue, irregular digestion, headaches, skin issues

Sample
Small blood sample collected at home – no fasting required

Report time
3-5 working days
2 Panels available
58+ foods (standard) up to 200+ expanded options

Common Symptoms
Bloating, fatigue, irregular digestion, headaches, skin issues

Sample
Small blood sample collected at home – no fasting required

Report time
3-5 working days
Best for: People with symptoms that appear hours or days after eating certain foods
Food Allergy Test
IgE Antibody Testing
Starts @₹5,000/-
Detect Immediate Allergic Reactions

4 Specialized Panels
Veg, Non-Veg, Inhalant, Drug Allergy, and Custom options

Common Symptoms
Hives, swelling, wheezing, vomiting, or shortness of breath

Sample
Small blood sample collected at home – no fasting required

Report time
3-5 working days
Panels available
Veg, Non-Veg, Inhalant, Drug Allergy, and Custom options

Common Symptoms
Hives, swelling, wheezing, vomiting, or shortness of breath

Sample
Small blood sample collected at home – no fasting required

Report time
3-5 working days
Best for: People with fast-onset symptoms or known allergic reactions
More Ways to Understand Your Gut Health
Beyond food sensitivities, explore deeper insights into your digestive health with our specialized tests

Gut Microbiome Test
DNA Sequencing Analysis
Your gut microbiome is home to trillions of bacteria that play a vital role in digestion, immunity, and mood balance. An imbalance in gut bacteria can cause bloating, acidity, constipation, weight gain, low energy, or poor immunity.

Type
Gut Microbiome DNA Sequencing

Measures
Beneficial vs. harmful bacteria balance

Sample
Stool sample (home collection available)

Report time
7–10 working days

Best For
People with chronic digestive issues or recurring fatigue.

Type
Gut Microbiome DNA Sequencing

Measures
Beneficial vs. harmful bacteria balance

Sample
Stool sample (home collection available)

Report time
7 -10 working days

Best For
People with chronic digestive issues or recurring fatigue
Starting from
₹6,000/-

H. Pylori Test
Stool Antigen Detection
Helicobacter pylori (H. pylori) is a common stomach bacterium linked to gastritis, ulcers, and acid reflux. If you suffer from acidity, bloating, stomach pain, or nausea, this test helps identify the infection early for effective treatment.

Type
Stool Antigen Test

Detects
Active H. pylori bacterial infection in the digestive tract

Sample
Stool sample (home collection available)

Report time
3–5 working days

Best For
People with chronic acidity, stomach pain, or indigestion

Type
Gut Microbiome DNA Sequencing

Measures
Beneficial vs. harmful bacteria balance

Sample
Stool sample (home collection available)

Report time
7 -10 working days

Best For
People with chronic digestive issues or recurring fatigue
Starting from
₹3,000/-
Real People, Real Results
Thousands have transformed their health by discovering their food triggers. Here’s what they have to say.

Your Wellness Path
Eat Better,
Feel Better!
Transform your health journey with science-backed testing and personalized nutrition guidance. Our comprehensive approach helps you identify problem foods and create a sustainable path to wellness.

Identify Triggers
Discover exactly which foods are causing your discomfort

Expert Support
Get personalized guidance from certified nutritionists

Feel Energized
Experience improved energy, mood, and overall wellbeing
Expert Guidance
Connect The Dots
With Our Experts
Get to the bottom of it with our experts. Understand not only the triggers, but also how to manage food intolerance, gluten intolerance, lactose intolerance, indigestion, constipation, bloating, acidity, stomach problems and check for food intolerance.

Rooted In Science
Trust the Science Behind Your
Health
Trust the Science Behind Your Health

NIH Research-Backed
Our testing methodology is based on peer-reviewed studies from the National Institutes of Health.

Clinical Precision
Lab-grade accuracy with comprehensive quality controls ensuring reliable results every time.

Expert Nutritionists
One-on-one consultation with certified nutritionists to help you interpret and act on your results.

Evidence-Based Reports
Detailed reports with scientific explanations and personalized dietary recommendations.

“Food sensitivities and intolerances can significantly impact quality of life. Identifying and eliminating trigger foods has shown remarkable improvements in gastrointestinal symptoms, skin conditions, and overall well-being.”
— Based on NIH Clinical Research Studies
Take Control of Your Health Today
Take Control of Your
Health Today
Your health is influenced by more than just what you eat. From food intolerances and allergies to gut microbiome imbalances and infections like H. pylori, multiple factors can impact your overall well-being. Advanced testing helps identify hidden triggers, understand your gut health, and take informed steps toward a healthier lifestyle.
Have questions? Our health experts are here to help
The News from Our Blog
Unveiling the Secret to a Happier Stomach: Food Intolerance Tests Online
The Convenience of Food Intolerance Tests Online: A Game Changer for Health-Conscious Individuals
The Convenience and Accuracy of Food Intolerance Tests Online
Frequently Asked Questions
Find answers to common questions about our food intolerance and allergy testing services
How will I receive my test report?
You will receive your report through WhatsApp, Email, and a hard copy sent by post. We ensure all reports are securely delivered for your convenience.
How long does it take to get the results?
You will receive your test results within 5 working days from the date of sample collection.
Is fasting required before the test?
No, fasting is not required. You can eat and drink normally before the sample collection.
Why should I get tested for Food Intolerance and Food Allergy?
Testing helps you take the guesswork out of your health and diet.
If you experience symptoms like bloating, fatigue, skin problems, or allergies, these tests can identify the foods or allergens responsible – allowing you to make informed dietary choices.
Do I need a doctor’s prescription to take the test?
No, a doctor’s prescription is not required. You can book the test directly from our website or by contacting our team.
How accurate are the results?
Your samples are tested in an NABL-accredited laboratory using advanced technology and strict quality control processes. Every sample is securely packed, labelled, and tracked to maintain integrity during transit. Our allergy and intolerance testing methods have a reproducibility rate of over 98%, meaning the same sample tested twice gives almost identical results. All tests are performed by qualified laboratory technicians using calibrated equipment to ensure precision and reliability.
How can I use my results with an elimination diet?
An elimination diet helps identify trigger foods by removing and reintroducing them one at a time. Your Food Intolerance Report includes a traffic-light system –
- Red = high reactivity
- Yellow = moderate reactivity
- Green = normal reactivity
Using this system, you’ll know which foods to limit or eliminate first. Our nutritionists can also guide you on how to create a practical eating plan and suggest suitable food alternatives to maintain a balanced diet.
What’s the difference between Food Intolerance and Food Allergy?
You will receive your report through WhatsApp, Email, and a hard copy sent by post. We ensure all reports are securely delivered for your convenience.
How will I receive my test report?
You will receive your report through WhatsApp, Email, and a hard copy sent by post. We ensure all reports are securely delivered for your convenience.
What’s the difference between Food Intolerance and Food Allergy?
Food Intolerance happens when your body struggles to digest certain foods or food components – it doesn’t involve the immune system and is not life-threatening.
Common symptoms include bloating, gas, stomach pain, and fatigue.
Food Allergy, on the other hand, involves an immune response where the body reacts immediately to certain food proteins. It can cause symptoms like rashes, swelling, wheezing, or even life-threatening anaphylaxis.
Both conditions require different approaches for diagnosis and management. Our Food Intolerance (IgG) and Food Allergy (IgE) tests help identify which foods or allergens are affecting you.





